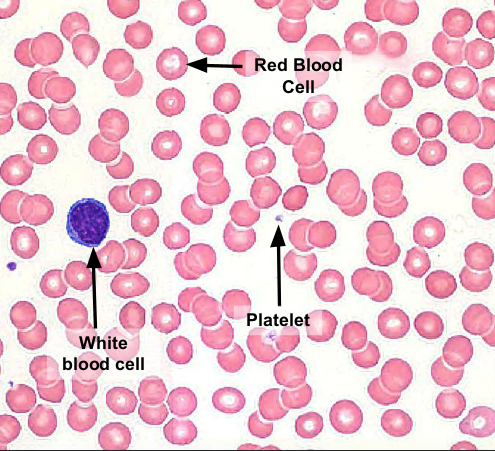
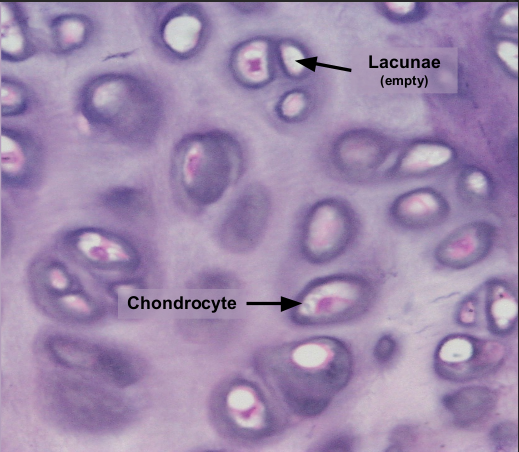

Connective and Nervous Tissue (Anatomy and Physiology)
1/42
There's no tags or description
Looks like no tags are added yet.
Name | Mastery | Learn | Test | Matching | Spaced |
|---|
No study sessions yet.
43 Terms
Areolar Connective Tissue
contains COLLAGEN fibers, ELASTIC fibers, and FIBROBLASTS
helps bind other tissues together and part of the INFLAMMATORY response

Areolar Connective Tissue is found between _______ and ___________.
skin, muscle

Adipose
contains LIPID STORAGE CELLS called ADIPOCYTES
stores ENERGY, ABSORBS shock, and provides INSULATION

Adipose is found in the _________, covering the __________ and ___________.
bottom layer of the skin, abdomen, and heart

Reticular tissue
contains RETICULAR BLOOD FIBERS that hold blood cells in place
stores both white and red blood cells

Reticular tissue is found in the _______, _____________, and ________________
spleen, bone marrow, and lymph nodes

Dense regular
tissue made mostly of COLLAGEN FIBERS with a FEW fibroblasts
provides connection between tissue that resist tension

Dense regular is found in _________ and __________.
ligaments, tendons

Blood
a type of FLUID connective tissue made of PLASMA, PLATELETS, RED, and WHITE BLOOD CELLS
transports oxygen and nutrients around the body/ carries O2
Blood is found within __________.
blood vessels

Cartilage
contains a matrix of PROTEINS and CHRONDROCYTES within small pits called lacunae

Lacunae
small pits (usually appearing white) that surround cells such as chondrocytes

Hyaline Cartilage
a matrix with a GLOSSY, SMOOTH, appearance
provides smooth surface and FLEXIBLE CONNECTION between tissues
Hyaline cartilage can be found in the ______ and _______.
respiratory tract, end of bones

Elastic cartilage
has a matrix with many ELASTIC FIBERS
withstand repetitive bending/manipulation, while maintaining original shape

Elastic cartilage can be found in the ____________.
external ear

Fibrocartilage
has FEWER cells and a matrix dense with COLLAGEN FIBERS
Highly RESISTANT to stretching and compression

Fibrocartilage can be found in ____________ and _____________.
Vertebral discs, pelvic cartilage

Bone
type of connective tissue that also has cells within LACUNAE
matrix has calcium phosphate

Bone is arranged in circular layers called __________.
lamellae

Bone helps provide ___________, ____________, and helps in ________________. They also have ________
structure, support, movement; osteoblast

Parts of connective tissue include a _________ and have names that end in ___________ or ___________. They help build shape and maintain connective tissue
nuclei, -cyte, -blast
4 different fibers in connective tissue
collagen fibers, elastic fibers, reticular fibers, ground substance
Collagen fibers
the THICKEST and STRONGEST fibers
Elastic fibers
THIN and STRETCHY fibers
Reticular fibers
THIN and CROSSLINKED
Ground substance
CLEAR, gel-like substance
Nervous tissue
cells that help transport electrical impulses to and from the brain - -contains long branched neurons and smaller neuroglia

Nervous tissue is mostly found in the __________ and ___________.
brain, spinal cord

Axon
long tail that extends from the neuron body, this transports electrical signals AWAY (A FOR AWAY!) from cell body to other neurons (muscles or glands) through a synapse

Myelin Sheath
this part wraps the axon and helps WRAP and SUPPORT the axon
maintains/ facilitates “ACTION POTENTIAL”

MS (Multiple Scelorsis)
autoimmune disease where myelin sheath is inflammed/irritated and body attacks myelin sheath
symptoms: loss in movement, weakness, fatigue blurred vision, emotional issues (depression, anxiety, etc.)
Dendrites
RECIEVES and PROCESS signals from other neurons
determine if neuron should send and electrical impulse

Synapse
the gap between two neurons where the gap allows for transmission of a signal

lymphocyte (white blood cells)
are IMMUNE CELLS that kill infected cells and produce antibodies
adipocyte
a large vesicle that STORES FAT as clear oil
erythrocytes
red blood cells that transport oxygen and carbon dioxide
chondrocytes
build the extracellular matrix of cartilage (found in small cavities called lacunae)
osteocyte
build and shape mineralized bone tissue (also found in lacunae)
__________ also help produce proteins in extracellular matrix but are NOT FOUND in cartilage.
Fibroblasts
Function of Connective Tissues
PROTECTION - hard coverings for delicate organs
ENERGY STORAGE - glycogen and triglycerides are kept in connective tissue
TRANSPORTATION - moves material around the body through lymph and blood
Organs
collection of tissues to form a common function
What structures help transport blood?
Arteries and veins
